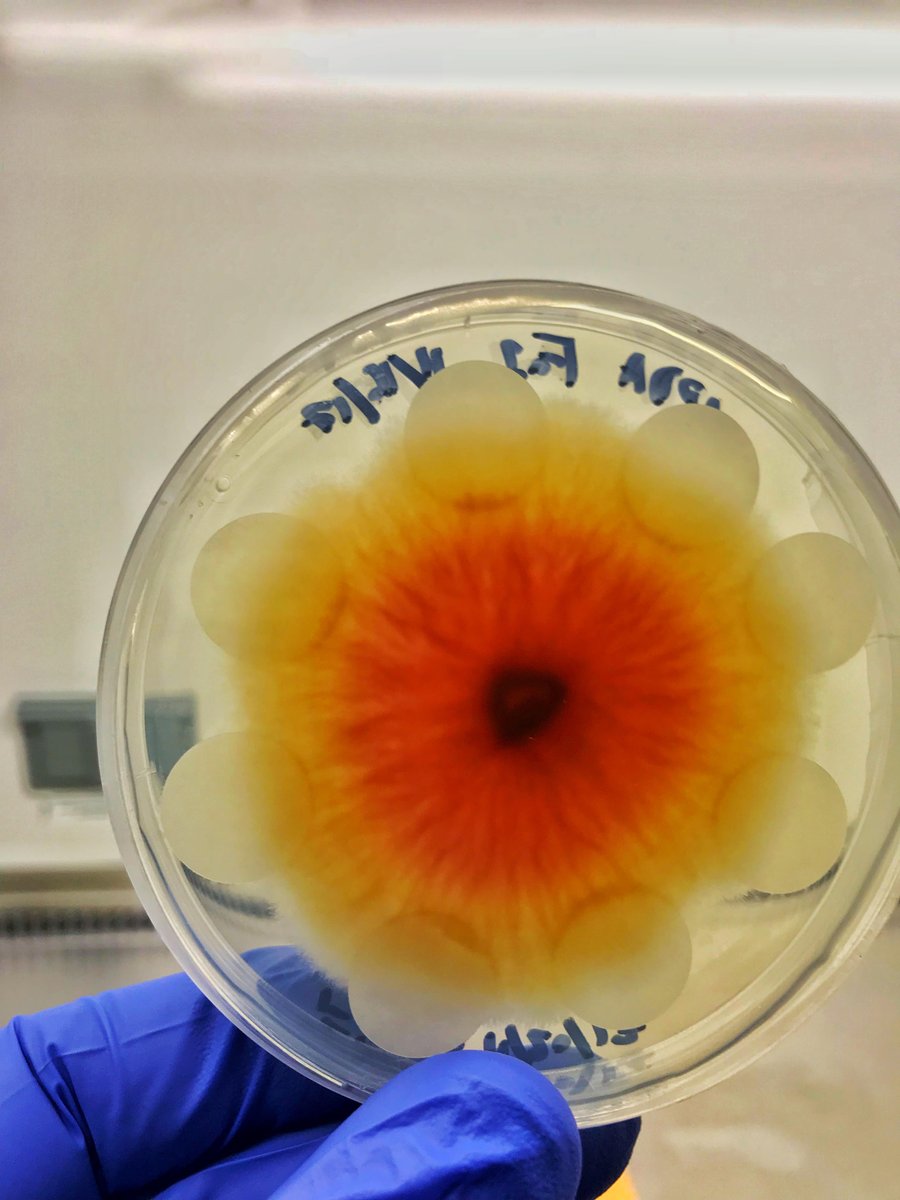
rhizorick's tweet image. Preserving 𝘍𝘶𝘴𝘢𝘳𝘪𝘶𝘮 𝘢𝘷𝘦𝘯𝘢𝘤𝘦𝘶𝘮 on filter discs for storage. Filter discs are removed after colonization, dried in sterile conditions, and frozen.
#mycology #fungalpathogen #lostinthemycoverse #weedscience #plantmicrobeinteractions #thispathogeniskindapretty

#fungalpathogen search results

#forest #Kretzschmaria deusta affecting a maple tree on Pacific Spirit Regional Park, Vancouver, BC #fungalpathogen #fungus @ubcforestry #forestpathogen


What a great find by @PankaSomogyi. Liometopum ant queen killed by an #entomopathogen #fungus #fungalpathogen

Thrilled w the recovery if two white #pine treated for #beetles and #fungalpathogen #blight Used #IPM #PHM #arborist #planthealthcare #www.betternature.solutions Caring for #trees does not need to poison #nature
Skin blotch disease suspected on garlic caused by Embellisia allii. We had to make sure to wash our cloves when we got home after dealing with this #fungalpathogen. #Ascomycota #garlicdiseases




"Landscape Connectivity Limits the Predicted Impact of #FungalPathogen Invasion" from Dr. Frank Pasmans Full text could be seen here: mdpi.com/2309-608X/6/4/…

Preserving 𝘍𝘶𝘴𝘢𝘳𝘪𝘶𝘮 𝘢𝘷𝘦𝘯𝘢𝘤𝘦𝘶𝘮 on filter discs for storage. Filter discs are removed after colonization, dried in sterile conditions, and frozen. #mycology #fungalpathogen #lostinthemycoverse #weedscience #plantmicrobeinteractions #thispathogeniskindapretty

Pleased to share our paper on deciphering differential physiological & molecular prerequisites of Conidial Anastomosis Tube & Germ Tube formation in C. gloeosporioides mdpi.com/1164854 Kudos @Nikita_myco2312 @serbonline @IndiaDST #fungalpathogen #cellfusion #transcriptome

Best summer job ever, visiting all the forests of MetroVancouver. I am looking for the fungal pathogen K. deusta (brittle cinder fungus). #forestry @ubcforestry @ubcLFS @sustainUBC #fungalpathogen #forestpathogen #fungus #Kretzschmaria

Longstanding MSL member Dr. Xin Li was appointed in Fall 2022 as a Canada Research Chair (CRC) in Plant Immunity. Learn more about Dr. Li's appointment and her research in #PlantImmunity and #FungalPathogen development: bit.ly/3YJSxXQ #IDWGS #IDWGIS #WomenInSTEM

⭐New on the blog from Martin Wilber ⭐ 🐸How do North American salamanders resist or tolerate an emerging fungal pathogen and why is it important? 📖Read the blog here! ow.ly/DhpF50DKV60 #fungalpathogen #chytrid

(1/2) @FDACSDPI & @UFTropical researchers confirm the presence of Pseudocerradoa paullulla (formerly named Puccinia paullulla), a #fungalpathogen, in Florida nurseries and urban landscapes.

Diversity of Cell Wall Related Proteins in Human Pathogenic Fungi sci.fo/49z #FungalPathogen #FungalCellWall #Glycosyltransferase

Had a great time in Louisiana catching snakes with Lafayette's USGS. Thanks for taking care of me and showing me what y'all do! #SFD #gottacatchthemall #fungalpathogen

Press coverage of the publication of Dr. Rupinder's lab. in EMBO Reports. #candida #fungalpathogen @DBTIndia @UllasKolthur thehindu.com/news/national/…. hyderabadmail.com/cdfd-researche…

Our new study @ubcmsl on the role of proteostasis in capsule and biofilm formation by the fungal pathogen Cryptococcus neoformans: microbialcell.com/researcharticl… #cryptococccus #lithium #fungalpathogen

Fungal infections kill more than 1.5 million people a year worldwide. We funded a @MoGen_Grad project at @UofT researching how #glycans play a key role in how a #fungalpathogen interacts with immune cells in the body. bit.ly/2tEf7r5

Effect of Castor #BeanOil on Post Harvest #FungalPathogen of Coconut: Lasiodiplodia theobromae..bit.ly/2pCjsZp

Cryptococcus neoformans is the "Microbe of the Month" in Trends in Microbiology. Short article by @Francois_Mayer1 and Jim Kronstad. #KronstadLab #fungalpathogen #ubcmsl @CellPressNews cell.com/trends/microbi…

The human #fungalpathogen Candida auris is classified by the #CDC as an urgent threat. Here, Shahi et al. determine its lipid composition, highlighting alterations in lipids that may be correlated to high drug resistance. academic.oup.com/femsyr/article… #FEMSYeastRes #DrugResistance

#SIF A review focuses on Alternaria alternata: the most common pathogen on date palm. @EcologicalAR @BasraUniversity #PlantPathology #FungalPathogen #Symptoms #DiseaseManagement #DatePalm Details: maxapress.com/article/doi/10…

#SIF #PlantPathology #FungalPathogen #Symptoms #DiseaseManagement #DatePalm @MaximumAcademic @BasraUniversity A review focuses on Alternaria alternata: the most common pathogen on date palm. Details: maxapress.com/article/doi/10…

Deadly fungal pathogens!!! #fungi #fungal #fungalpathogen cnn.com/2025/05/24/cli…
cnn.com
A fungus that can ‘eat you from the inside out’ could spread as the world heats up | CNN
Infection-causing fungi responsible for millions of deaths a year will spread significantly to new regions as the planet heats up, new research predicts —and the world is not prepared.
Miconazole Nitrate 2% Antifungal Cream – Fast Relief for Athlete’s Foot! youtu.be/TEJUGaJFlzM?si… #fungalpathogen #CreamHeart #Fast #Athletics #FootFit #FridayVibes

youtube.com
YouTube
Miconazole Nitrate 2% Antifungal Cream – Fast Relief for Athlete’s...
Decoding Fungal Virulence: The Role of Chromatin Structure in Postharvest Pathogens newswise.com/articles/decod… @CAS__Science #fungal #FungalTreatment #fungalpathogen #fungalnailtreatment

Press coverage of the publication of Dr. Rupinder's lab. in EMBO Reports. #candida #fungalpathogen @DBTIndia @UllasKolthur thehindu.com/news/national/…. hyderabadmail.com/cdfd-researche…

Press coverage of the publication of Dr. Rupinder's lab. in EMBO Reports. #candida #fungalpathogen @DBTIndia @UllasKolthur hyderabadmail.com/cdfd-researche… timesofindia.indiatimes.com/city/hyderabad…
timesofindia.indiatimes.com
Groundbreaking Research Reveals How Candida glabrata Evades Immune Defense | Hyderabad News - Times...
Discover the new findings from CDFD researchers on how the fungal pathogen Candida glabrata evades the immune system, leading to severe infections in immunocompromised individuals. Learn about the...
Alteration of β-glucan in the emerging fungal pathogen Candida auris leads to immune evasion and increased virulence Akses jurnal: scholar.ui.ac.id/en/publication… #FungalPathogen #Research #UniversitasIndonesia
Fungal Pathogen Behind Banana Wipeout Identified 🍌 🔗azolifesciences.com/news/20240819/… #fungalpathogen #banana #bananafungus
azolifesciences.com
Fungal Pathogen Behind Banana Wipeout Identified
The fungal pathogen Fusarium oxysporum f.sp. cubense (Foc) tropical race 4 (TR4) is the source of the disease Fusarium wilt of banana (FWB), which is threatening to functionally wipe out the bananas...
📣🫐🫐Research article in JoF "Genome Analyses of Two Blueberry Pathogens: 𝘋𝘪𝘢𝘱𝘰𝘳𝘵𝘩𝘦 𝘢𝘮𝘺𝘨𝘥𝘢𝘭𝘪 CAA958 and 𝘋𝘪𝘢𝘱𝘰𝘳𝘵𝘩𝘦 𝘦𝘳𝘦𝘴 CBS 160.32" Read the full-text here: mdpi.com/2309-608X/8/8/… #Blueberry #FungalPathogen #Genome

✅ Check our preprint to learn how C. auris utilizes CO2 to deal with stress during environmental and host adaptation. 📷 Link: biorxiv.org/content/10.110… 3/3 #GreenHouseGas #CO2 #FungalPathogen #Cauris
Could someone explain to me why an #artificialyeast cell could not become a serious human #fungalpathogen just by chance? Asking for a bunch of scientists worried about #GOF research and doing things ‘because we can’ digitaleditions.telegraph.co.uk/data/1512/read…
Skin blotch disease suspected on garlic caused by Embellisia allii. We had to make sure to wash our cloves when we got home after dealing with this #fungalpathogen. #Ascomycota #garlicdiseases




On 6.29.23, join Dr. Minh-Hong Nguyen from @upmc, Dr. Lucy Witt & Dr. Gavin Harris from @EmoryMedicine, & Dr. Meghan Lyman from @CDCgov for a #ProjectECHO session on #CandidaAuris, a #FungalPathogen case study, & the CDC response to the current outbreak: zoom.us/webinar/regist…


What a great find by @PankaSomogyi. Liometopum ant queen killed by an #entomopathogen #fungus #fungalpathogen

Press coverage of the publication of Dr. Rupinder's lab. in EMBO Reports. #candida #fungalpathogen @DBTIndia @UllasKolthur thehindu.com/news/national/…. hyderabadmail.com/cdfd-researche…

#forest #Kretzschmaria deusta affecting a maple tree on Pacific Spirit Regional Park, Vancouver, BC #fungalpathogen #fungus @ubcforestry #forestpathogen


(1/2) @FDACSDPI & @UFTropical researchers confirm the presence of Pseudocerradoa paullulla (formerly named Puccinia paullulla), a #fungalpathogen, in Florida nurseries and urban landscapes.

Skin blotch disease suspected on garlic caused by Embellisia allii. We had to make sure to wash our cloves when we got home after dealing with this #fungalpathogen. #Ascomycota #garlicdiseases




Pleased to share our paper on deciphering differential physiological & molecular prerequisites of Conidial Anastomosis Tube & Germ Tube formation in C. gloeosporioides mdpi.com/1164854 Kudos @Nikita_myco2312 @serbonline @IndiaDST #fungalpathogen #cellfusion #transcriptome

⭐New on the blog from Martin Wilber ⭐ 🐸How do North American salamanders resist or tolerate an emerging fungal pathogen and why is it important? 📖Read the blog here! ow.ly/DhpF50DKV60 #fungalpathogen #chytrid

The human #fungalpathogen Candida auris is classified by the #CDC as an urgent threat. Here, Shahi et al. determine its lipid composition, highlighting alterations in lipids that may be correlated to high drug resistance. academic.oup.com/femsyr/article… #FEMSYeastRes #DrugResistance

"Landscape Connectivity Limits the Predicted Impact of #FungalPathogen Invasion" from Dr. Frank Pasmans Full text could be seen here: mdpi.com/2309-608X/6/4/…

Cryptococcus neoformans is the "Microbe of the Month" in Trends in Microbiology. Short article by @Francois_Mayer1 and Jim Kronstad. #KronstadLab #fungalpathogen #ubcmsl @CellPressNews cell.com/trends/microbi…

📣🫐🫐Research article in JoF "Genome Analyses of Two Blueberry Pathogens: 𝘋𝘪𝘢𝘱𝘰𝘳𝘵𝘩𝘦 𝘢𝘮𝘺𝘨𝘥𝘢𝘭𝘪 CAA958 and 𝘋𝘪𝘢𝘱𝘰𝘳𝘵𝘩𝘦 𝘦𝘳𝘦𝘴 CBS 160.32" Read the full-text here: mdpi.com/2309-608X/8/8/… #Blueberry #FungalPathogen #Genome

Our new study @ubcmsl on the role of proteostasis in capsule and biofilm formation by the fungal pathogen Cryptococcus neoformans: microbialcell.com/researcharticl… #cryptococccus #lithium #fungalpathogen

Preserving 𝘍𝘶𝘴𝘢𝘳𝘪𝘶𝘮 𝘢𝘷𝘦𝘯𝘢𝘤𝘦𝘶𝘮 on filter discs for storage. Filter discs are removed after colonization, dried in sterile conditions, and frozen. #mycology #fungalpathogen #lostinthemycoverse #weedscience #plantmicrobeinteractions #thispathogeniskindapretty
Longstanding MSL member Dr. Xin Li was appointed in Fall 2022 as a Canada Research Chair (CRC) in Plant Immunity. Learn more about Dr. Li's appointment and her research in #PlantImmunity and #FungalPathogen development: bit.ly/3YJSxXQ #IDWGS #IDWGIS #WomenInSTEM

#SIF A review focuses on Alternaria alternata: the most common pathogen on date palm. @EcologicalAR @BasraUniversity #PlantPathology #FungalPathogen #Symptoms #DiseaseManagement #DatePalm Details: maxapress.com/article/doi/10…

Best summer job ever, visiting all the forests of MetroVancouver. I am looking for the fungal pathogen K. deusta (brittle cinder fungus). #forestry @ubcforestry @ubcLFS @sustainUBC #fungalpathogen #forestpathogen #fungus #Kretzschmaria

On 6.29.23, join Dr. Minh-Hong Nguyen from @upmc, Dr. Lucy Witt & Dr. Gavin Harris from @EmoryMedicine, & Dr. Meghan Lyman from @CDCgov for a #ProjectECHO session on #CandidaAuris, a #FungalPathogen case study, & the CDC response to the current outbreak: zoom.us/webinar/regist…

Diversity of Cell Wall Related Proteins in Human Pathogenic Fungi sci.fo/49z #FungalPathogen #FungalCellWall #Glycosyltransferase

Had a great time in Louisiana catching snakes with Lafayette's USGS. Thanks for taking care of me and showing me what y'all do! #SFD #gottacatchthemall #fungalpathogen

Something went wrong.
Something went wrong.
United States Trends
- 1. #StrangerThings5 249K posts
- 2. Thanksgiving 675K posts
- 3. BYERS 56.7K posts
- 4. robin 92.2K posts
- 5. Reed Sheppard 5,869 posts
- 6. Afghan 287K posts
- 7. holly 64.4K posts
- 8. Podz 4,503 posts
- 9. Dustin 89.8K posts
- 10. Vecna 58.8K posts
- 11. National Guard 662K posts
- 12. Jonathan 75K posts
- 13. hopper 16K posts
- 14. Erica 17.5K posts
- 15. Lucas 83.3K posts
- 16. Nancy 68.3K posts
- 17. Gonzaga 8,519 posts
- 18. Joyce 32.1K posts
- 19. noah schnapp 8,970 posts
- 20. Tini 9,578 posts



























